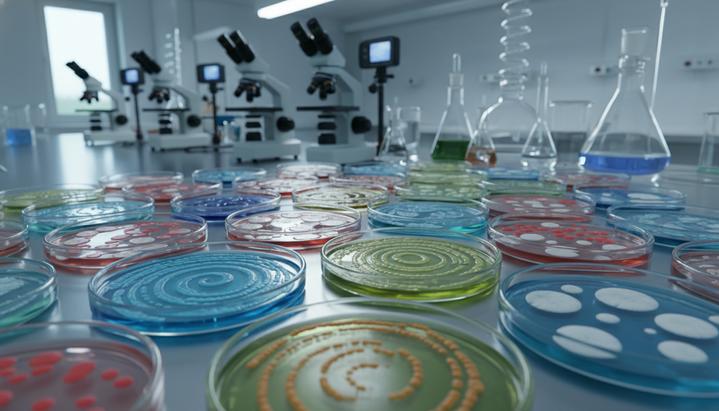
Лабораторный стол с чашками Петри, в которых видны колонии бактерий. На заднем плане размытое научное оборудование.

Ученые определили конкретные кишечные бактерии и биологические процессы, которые приводят к выработке алкоголя внутри организма у людей с «синдромом автопивоварни». Это редкое и часто неправильно диагностируемое состояние заставляет людей испытывать опьянение, даже если они не употребляли спиртное. Исследование, опубликованное в журнале Nature Microbiology, было проведено командой из Mass General Brigham в сотрудничестве с Калифорнийским университетом в Сан-Диего.
«Синдром автопивоварни» развивается, когда определенные микробы в кишечнике расщепляют углеводы и преобразуют их в этанол – спирт, который затем попадает в кровоток. Хотя в процессе обычного пищеварения у любого человека может образовываться незначительное количество алкоголя, у людей с этим синдромом его уровень может быть достаточно высоким, чтобы вызвать заметное опьянение. Из-за недостаточной осведомленности, трудностей с диагностикой и социальной стигмы многие пациенты годами живут без правильного диагноза, сталкиваясь с социальными, медицинскими и даже юридическими проблемами.
Чтобы изучить биологические корни расстройства, исследователи проанализировали состояние 22 пациентов с диагностированным синдромом, а также 21 здорового члена их семей и 22 участников из контрольной группы. Команда сравнила состав и активность кишечных микробов во всех группах, чтобы выявить ключевые различия. Лабораторные тесты показали, что образцы стула, взятые у пациентов во время обострения симптомов, производили значительно больше этанола, чем образцы здоровых людей. Это открытие открывает возможность разработки простого и надежного теста на основе анализа стула.
До недавнего времени у ученых было мало информации о том, какие именно микроорганизмы – дрожжи или бактерии – ответственны за развитие синдрома. Детальный анализ выявил нескольких ключевых «виновников», включая такие виды бактерий, как кишечная палочка (Escherichia coli) и Klebsiella pneumoniae. У некоторых пациентов во время обострений также наблюдался гораздо более высокий уровень ферментов, участвующих в процессах брожения.
Команда также наблюдала за одним пациентом, чье состояние улучшилось после трансплантации фекальной микробиоты – процедуры, которая помогла, когда другие методы лечения оказались неэффективны. Периоды рецидива и выздоровления пациента точно совпадали с изменениями в конкретных штаммах бактерий и метаболической активности в его кишечнике. После второй трансплантации, проведенной с использованием другого протокола, пациент оставался без симптомов более 16 месяцев.
«Синдром автопивоварни» – это малоизученное состояние с ограниченными возможностями для тестирования и лечения. Наше исследование демонстрирует потенциал фекальной трансплантации», – заявила соавтор работы доктор Элизабет Хоманн. Она добавила, что определение конкретных бактерий и микробных путей, ответственных за синдром, может проложить путь к более простой диагностике, эффективному лечению и улучшению качества жизни людей, живущих с этим редким заболеванием.


